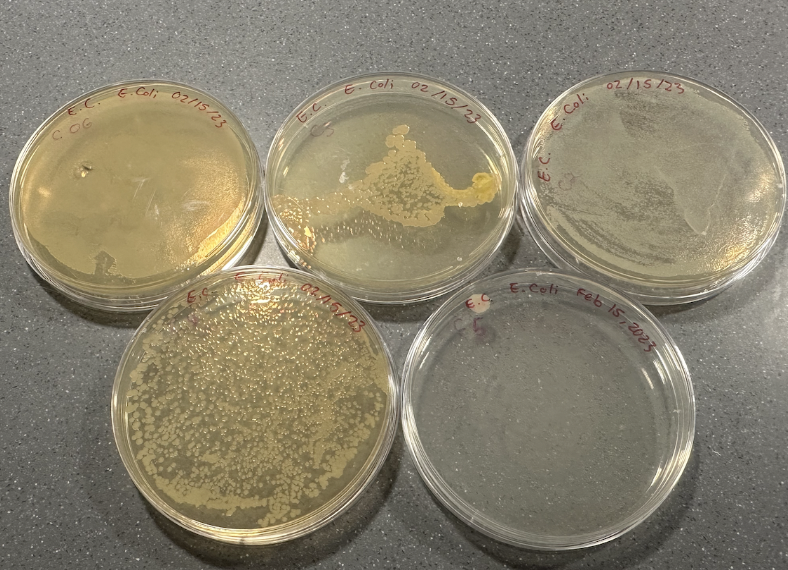
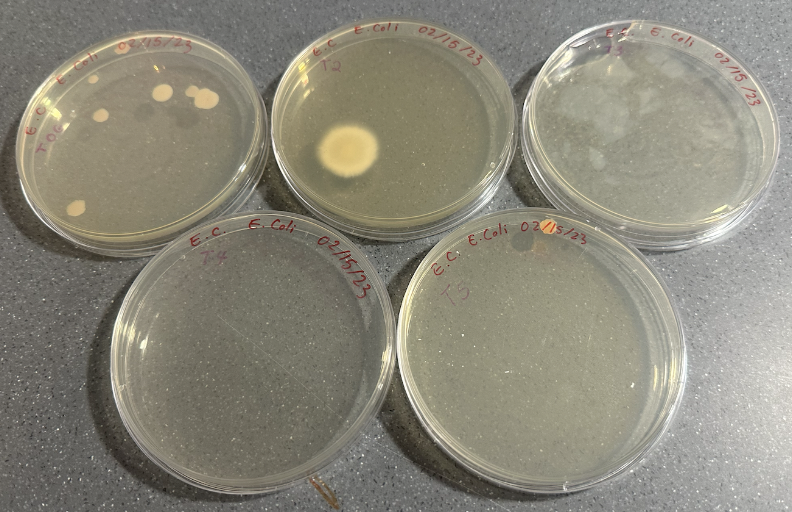
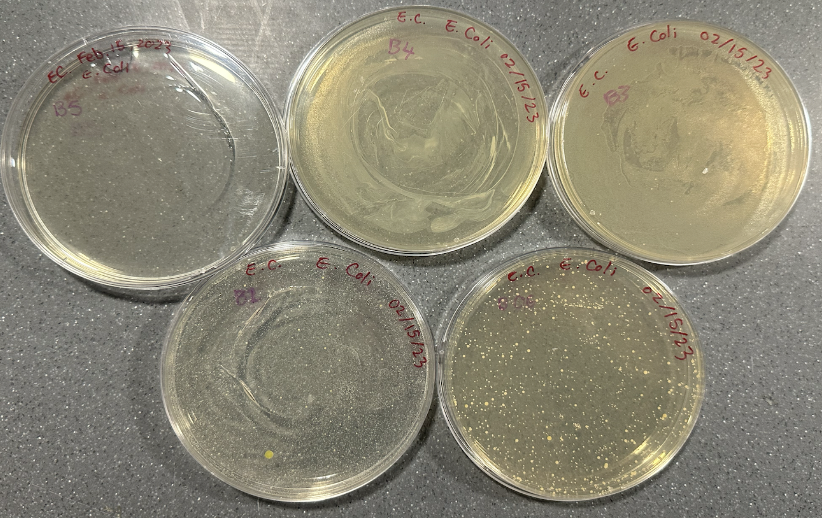

Emily Cao, Life Science
Abstract
The lack of clean drinking water is one of the most severe global issues of the modern day. Despite freshwater being a renewable resource, its accessibility is still limited and people continue to die from water-borne illnesses and diseases. In this experiment, three distinct methods of simplistic water purification are tested for its effectiveness. Purification tablets were concluded to be the most effective and cost efficient when purifying E. coli infected water.
Introduction
Water purification is the process of removing undesirable chemicals, biological contaminants, suspended solids, and gasses from contaminated water. (Water Purification » Ecologix Systems, n.d.). One of the major challenges in removing these contaminants from water in many developing countries is the elimination of microorganisms which cause common diseases such as Cryptosporidium, Campylobacter, and rotaviruses.(Thompson, 2014) These highly contagious diseases are caused by parasites and bacteria that severely infect the intestines of humans and cause diarrhea, with some cases being fatal for individuals with weak immune systems. Other frequently found but not limited to contaminants of water include Salmonella, Shigella., Vibrio, pathogenic E. coli, Acinetobacter, and Aeromonas. Stock pollutants compromise non-biodegradable plastics, synthetic chemical and heavy metals that have limited absorptive capacity. (Chaudhry & Malik, 2017)
Today, much research has already been performed on effective water purification methods. In many developed countries, the implemented processes of water purification involve advanced technology in drinking water treatment plants, typically using coagulation and filtration then followed by disinfection. Advanced water treatment processes include reverse osmosis, membrane filtration, and water oxidation. (UC Riverside) The most common methods of purification in developing countries were: DIY water filters, hand pumps, media filtration (sand and sediment filtration), reverse osmosis (RO), chemical radiation (UV), and flocculation/coagulation with sedimentation. (Foster, 2017)
The most feasible and cost-efficient methods of water purification needs to be determined and implemented in developing countries immediately, in order to solve this global water crisis. Furthermore, according to The World Bank, by 2050, nearly 7 out of 10 people will live in cities. This implies that water purification systems will increasingly be aggregated in one area, therefore creating the need for simpler, but effective methods of water purification for many developing communities. (Urban Development Overview, n.d.) Inevitably, there will be limitations to what can be implemented in a certain geographical area. For instance, environmental restrictions and technological accessibility will have a significant influence for a city. However, first, the primary objective is to determine the method of water purification that is both equally effective and cost-efficient, aimed to increase the availability of clean and potable water in many developing countries around the world.
For this experiment, the chosen contaminant is Escherichia coli (E. coli), one of the most common bacteria found in water that can lead to serious damage in the linings of intestines and kidneys, possibly being fatal. E. coli is a gram-negative, rod-shaped bacterium that originates in the intestines of many animals and consequently, their feces, often found in sewage waste. (“Where Does E. coli in Water Come From?”) There are more than seven hundred serotypes of E. coli identified and although some most strains are benign, some strains such as E. coli O157:H7 can cause severe intestinal infection in humans when ingested. (“Escherichia coli (E. coli) – MN Dept. of Health”)
Materials and Methods
The bacteria experimented with was E. coli K12. Safety precautions were taken before conducting the experiment. Petri dishes with existing E. coli K12 were replated and grown in order for enough colonies to continue research. Thirty LB agar nutrient plates were made and labeled before beginning E. coli growth. Three different methods of water purification were used: activated charcoal (Seapora), water purification tablets (Aquatabs) and traditional boiling. All tested samples were obtained through mixing a solution of 10mL of distilled water with 1 colony of E. coli K12 (130,00,000 cells) in test tubes. A total of four distinct solutions were made.
Activated Charcoal
The activated charcoal was first ground into a fine powder with a mortar and pestle. The recommended ratio of activated charcoal to water was 50g to 1L. The determined ratio of activated charcoal mixed with distilled water was 0.5g to 10mL. 0.5g of activated charcoal was mixed with 10mL distilled water and 1 colony of E. coli in order to satisfy the standardized test samples of 10mL. The solution was set aside for 30 minutes for purification.
Water Purification Tablets
The purification tablets were first grinded into a fine powder with a mortar and pestle. Each tablet contained 49 mg of sodium Dichloroisocyanurate / NaDCC (Troclosene Sodium), Sodium Bicarbonate, Adipic Acid and Sodium Carbonate. The determined ratio of purification tablets mixed distilled water was approximately 0.02g/500mL. The 0.02g of the powder was mixed with 10mL distilled water and 1 colony of E. coli to satisfy the standardized test samples of 10mL. The solution was set aside for 30 minutes for purification.
Traditional Boiling
A 50mL beaker containing 12mL of distilled water mixed with 1 colony of E. coli was heated to boiling. The amount of 12mL of distilled water was chosen due to the evaporation of water during heating. After heating, the solution of 10mL was poured into a test tube.
Serial Dilution
Each test tube sample went through the same process of serial dilution. Each test tube contained 1.3×108 E. coli cells and underwent five dilutions. A pipette was used to take out 1mL of the solution from the original test tube and then mixed with 9mL of distilled water. The last dilution was expected to have 13,000 cells (1.3×104).
The positive control test tube contained 10mL of distilled water mixed with 1 colony of E. coli. The positive control went through the same process serial dilution, however only the original (1.3×108 cells), dilution two, three and four were replated for regrowth.
Subsequent to the serial dilution for all the four solutions, a pipette was used to take out 200uL (0.2mL) of the solution and replated on the agar petri dishes for regrowth. A bent glass rod was then sterilized and used to evenly spread out the solution on the agar. The petri dishes were then set aside for incubation. The replated petri dishes were then taken out and results were analyzed. For each three methods of purification, the most countable petri-dish was chosen to be analyzed for data. Four quadrants were drawn on the petri-dish and colonies were manually determined (counting ones touching the lines and in between). The average diameter of the colonies were also determined by averaging the diameter of three different colonies selected at random.
Results
All petri dishes exhibited either no E. coli growth, E. coli colonies, E. coli lawns or fungal contamination.
Table 1. Quantitative and qualitative results of petri dishes after serial dilution of 3 different purification methods and the positive control.


Figure 1. Petri-dishes exhibiting the positive control with fungal contamination.
Figure 2. Petri-dishes containing the serial diluted E. coli regrowth for activated charcoal tablets from highest to lowest concentration.
Figure 3. Petri-dishes containing the serial diluted E. coli regrowth for water purification tablets from highest to lowest concentration.
Figure 4. Petri-dishes containing the serial diluted E. Coli regrowth for traditional boiling from highest to lowest concentration.
Cell Growth Analysis
Due to the inconsistency of the results, one petri dish (the most countable one) was used to compare the current number of cell growth to the original number of cells in the 10mL of solution. Petri dishes of activated charcoal dilution 4 (1.3×104 cells) and boiling original (1.3×108 cells) were chosen for colony counting. 271 colonies with an average diameter of 2mm were determined for one quadrant of activated charcoal dilution 4 (1.3×104 cells, resulting in 1084 colonies for all four quadrants. 190 colonies with an average diameter of 1mm were determined for one quadrant of boiling original (1.3×108 cells), resulting in 760 colonies for all four quadrants. No lawns or colonies were detected for any of the purification tablets treatments.
Discussion
The water purification tablets were determined to be the most effective at eliminating E. coli growth. The serial dilution reflected that the bacteria had been killed immediately (no cell growth except for the expected positive control). Through the counting of colonies for both activated charcoal and boiling, a significant increase in colonies, and therefore cells, is shown in comparison to its respective original dilution concentration. These results indicate that the experiment was inconclusive. A purification method was determined to be the most effective, however the progression of serial dilution effects is unclear.
Due to the multistep nature of this experiment, the margin of error was significant. The process of creating the 10mL of distilled water and E. Coli solution was also not the most accurate as the colonies used were not all perfectly uniform in size. Although best efforts were made to ensure no contamination, because of other peer projects occurring on the same workbench and general space, cross contamination was possible. Another possible causation of error was the process of weighing out the appropriate amounts of water purification tablets and activated charcoal. Because of the incompatible shape and sizes of the prepackaged water purifiers, both the purification tablet and activated charcoal required grinding and weighing before use. These actions significantly increased the chance of inaccuracy and therefore, may have ultimately impacted the results of this experiment.
Although the water purification tablets were determined to be the most effective method of purification, further research on these tablets will need to be conducted. These purification tablets, a chlorine-based solution, can eliminate a variety of bacteria (such as E. coli) and protozoa (single-cell organisms which commonly lead to malaria), however, are not effective against many other forms of pathogens. These include pathogen species such as Cryptosporidium oocysts, Cyclospora, and worm eggs which are proven to be immune to many commercial disinfectants. Chlorine and several even stronger forms of disinfectants such as ethanol, methanol and chlorhexidine will not have a strong influence in barricading the embryonic development of many parasitic worms. (Oh et al., 2016) Therefore, efforts will need to be made in the direction of determining possible improvements or innovation of these purification tablets in order to combat even more potent bacteria and pathogens globally. Further experiments could be to replicate the serial dilution element in this experiment to ensure that the results were not due to chance. Then, other bacteria or contaminants can be incorporated to be tested on for extensive research on the abilities of this particular water purifier.
References
(n.d.). CRYPTOSPORIDIOSIS. Retrieved December 13, 2022, from https://dhss.delaware.gov/dph/files/cryptosfaq.pdf
Black+Blum UK. “Charcoal Water Filter.” Black+Blum UK, https://black-blum.com/pages/charcoal-water-filter#:~:text=How%20much%20charcoal%20do%20I,charcoal%20per%201litre%20of%20water.
Chaudhry, F., & Malik, M. (2017, March 31). Factors Affecting Water Pollution: A Review. OMICS International. Retrieved December 13, 2022, from https://www.omicsonline.org/open-access/factors-affecting-water-pollution-a-review-2157-7625-1000225.php?aid=87940#3
Escherichia Coli (E. Coli). Escherichia Coli (E. Coli) – MN Dept. of Health, https://www.health.state.mn.us/diseases/ecoli/index.html.
Foster, J. E. (2017, March 23). Plasma-based water purification: Challenges and prospects for the future. AIP Publishing. Retrieved December 13, 2022, from https://d1wqtxts1xzle7.cloudfront.net/34540672/feasibility-of-water-purification-technology-in-rural-areas-of-developing-countries.original-libre.pdf?1409049101=&response-content-disposition=inline%3B+filename%3DFeasibility_of_Water_Purification_Techno.pdf
Global WASH Fast Facts | Global Water, Sanitation and Hygiene | Healthy Water. (2022, May 31). CDC. Retrieved December 13, 2022, from https://www.cdc.gov/healthywater/global/wash_statistics.html
Oh, K.-S., Kim, G.-T., Ahn, K.-S., & Shin, S.-S. (2016, February 26). Effects of Disinfectants on Larval Development of Ascaris suum Eggs. NCBI. Retrieved December 13, 2022, from https://www.ncbi.nlm.nih.gov/pmc/articles/PMC4792319/
Thompson, M. (2014, May 27). A critical review of water purification technology appropriate for … UCLA Institute of the Environment and Sustainability. Retrieved December 13, 2022, from https://www.ioes.ucla.edu/wp-content/uploads/A-Critical-Review-Of-Water-Purification-Technology-Appropriate-For-Developing-Countries-Northern-Ghana-As-A-Case-Study.pdf
Urban Development Overview. (n.d.). World Bank. Retrieved December 13, 2022, from https://www.worldbank.org/en/topic/urbandevelopment/overview
Water purification » Ecologix Systems. (n.d.). Ecologix Environmental Systems. Retrieved December 12, 2022, from https://www.ecologixsystems.com/library-water-purification/
“What Are Advanced Water Treatment Processes?” UC Riverside, 27 July 2020, https://engineeringonline.ucr.edu/blog/what-are-advanced-water-treatment-processes/.
Where Does E. Coli in Water Come from? The Berkey, https://theberkey.com/blogs/water-filter/where-does-e-coli-in-water-come-from.